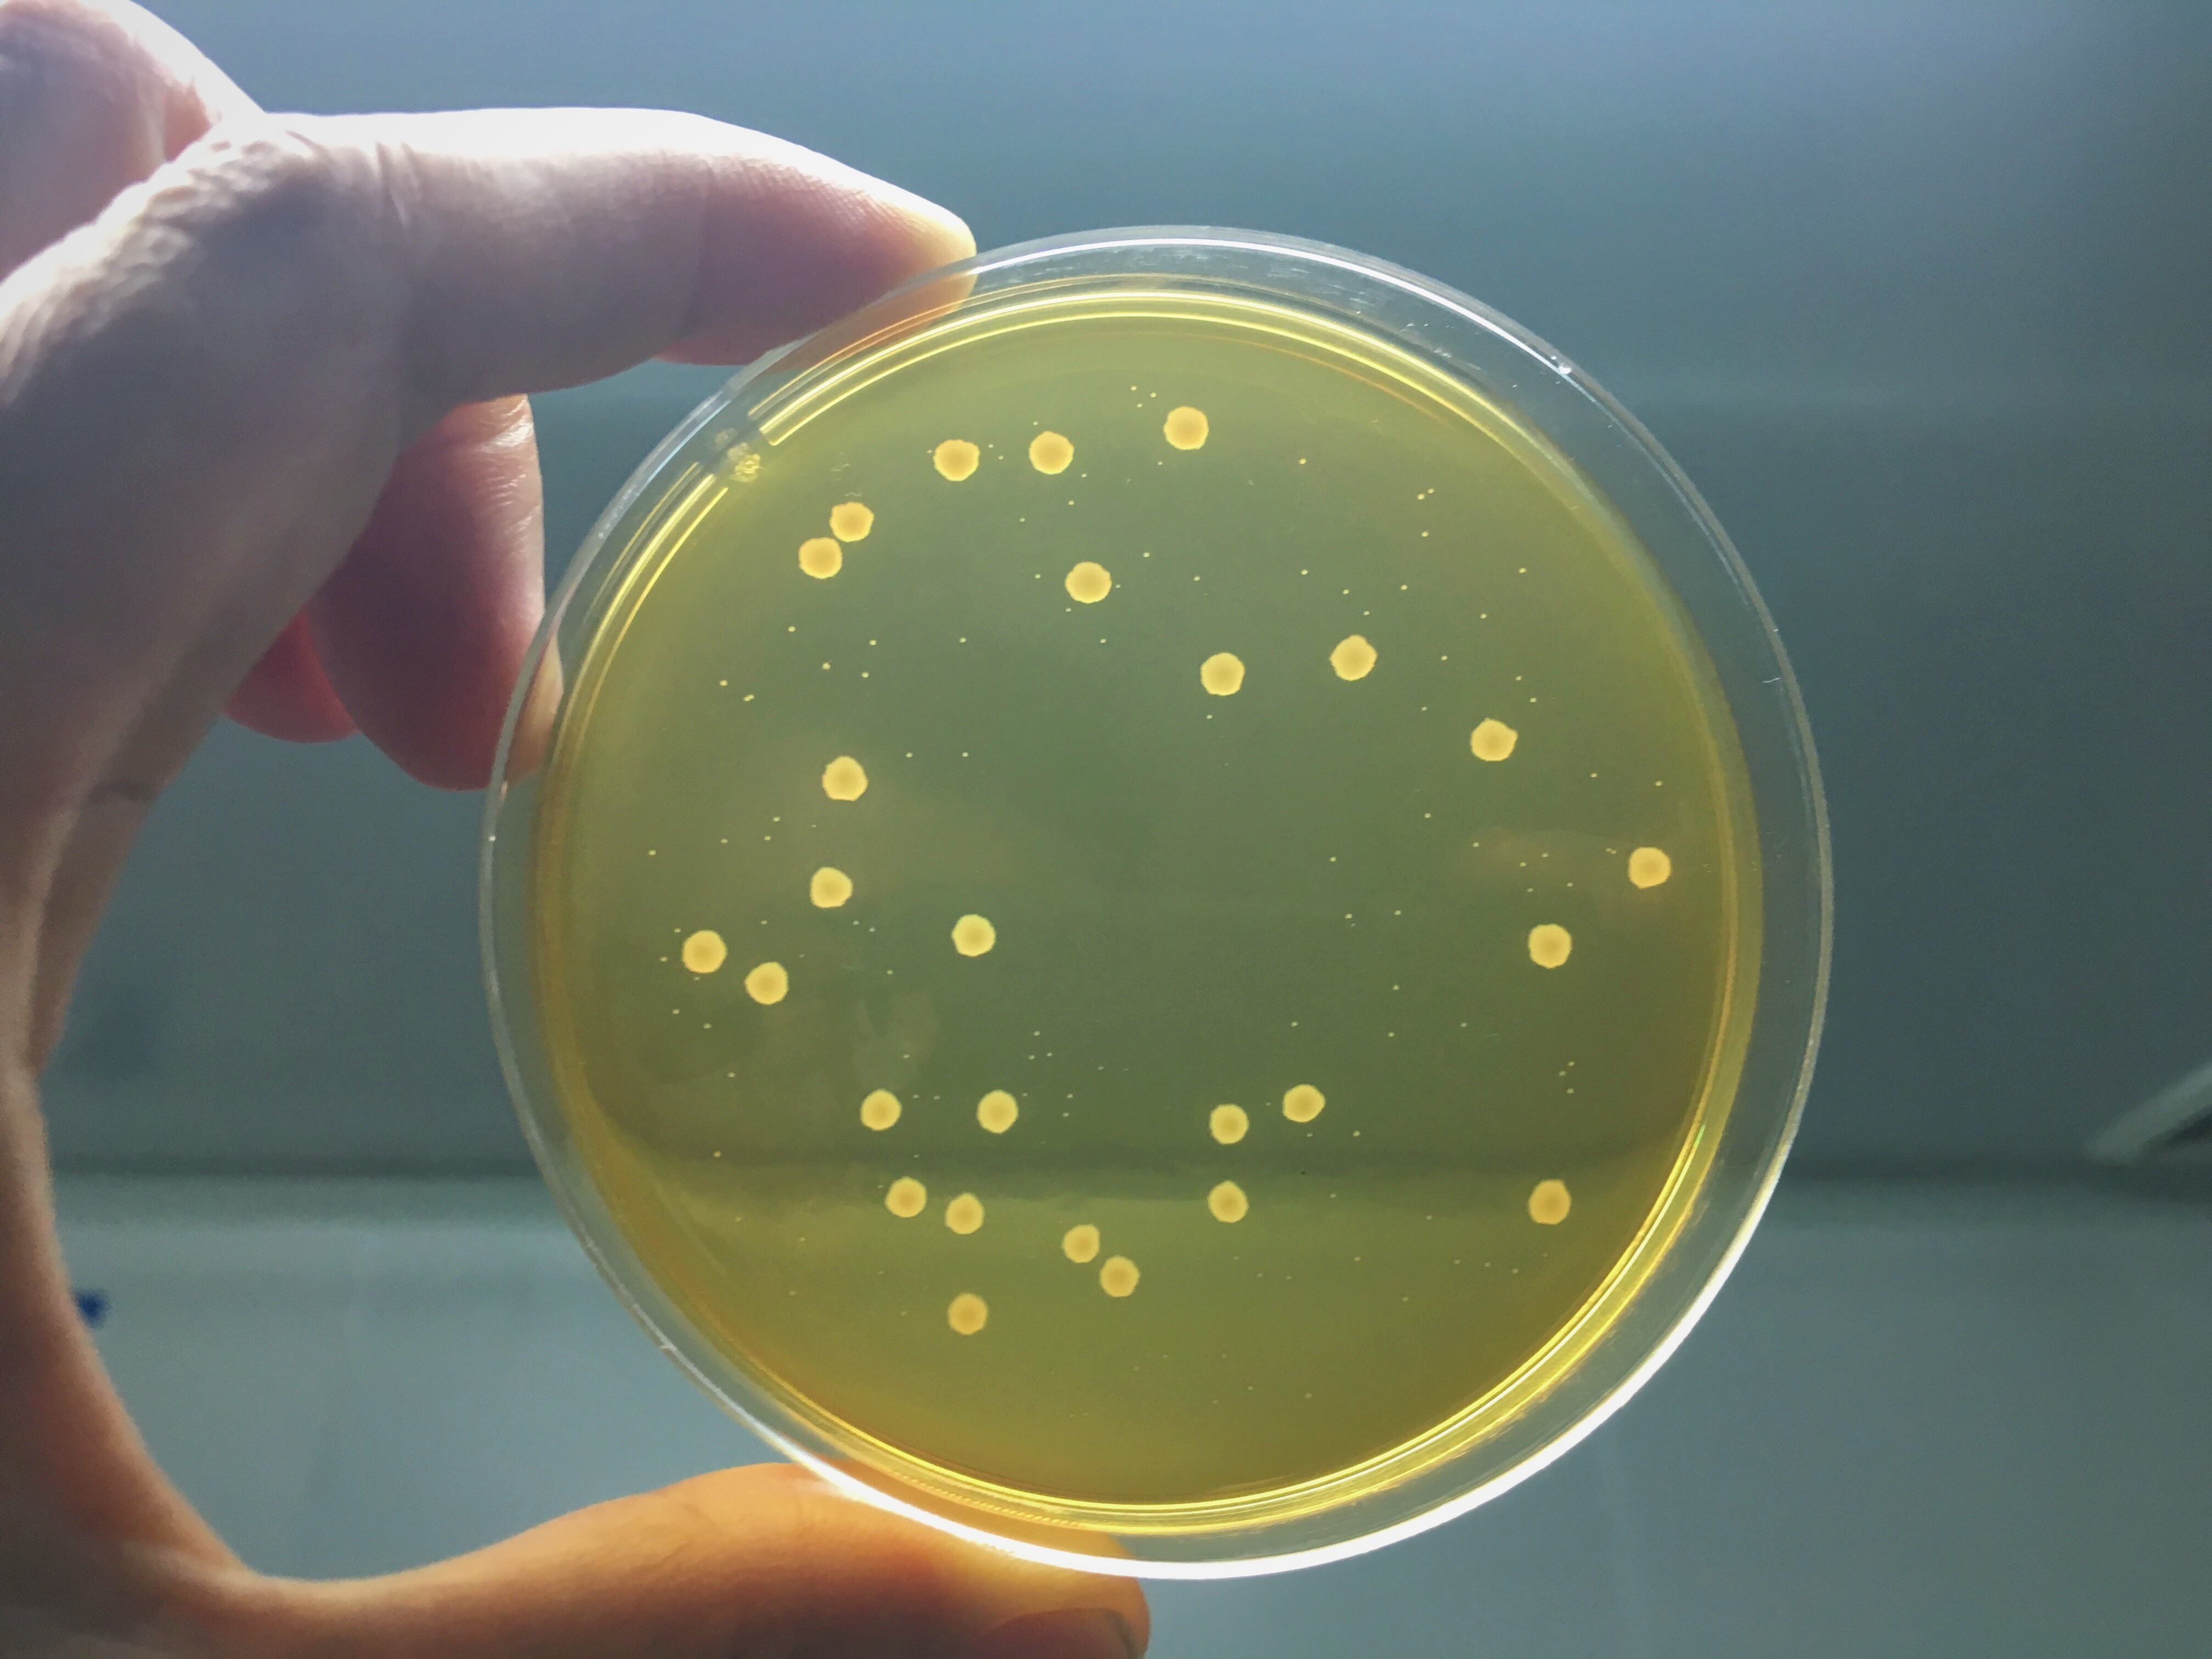

The Natural Alternative
At our production facility in Oldenzaal (EU), we can produce Bacillus strains on a large scale. We develop these natural alternatives together with our clients by fermenting Bacillus bacteria. We research, improve, and produce these biological intermediate or final products. In our production facility, we have fermenters ranging from 500 to 40,000 liters.